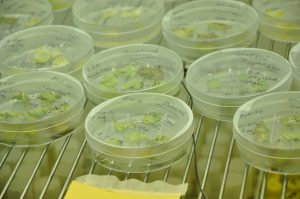

Noticias destacadas
02/05/23
Avanza la biotecnología en el desarrollo de la agricultura nacional
En los próximos días se realizará el 9° Congreso Nacional e Internacional de Agrobiotecnología, en donde especialistas del INTA analizarán el aporte de la biotecnología en la agricultura del futuro.
En un contexto mundial en el que la producción de alimentos está cada vez más afectada por el cambio del clima, los avances tecnológicos innovadores se vuelven una prioridad de cara a lograr una producción más eficiente, certera y previsora. En este contexto, el INTA lidera el avance de la agrobiotecnología en el país mediante el desarrollo de múltiples productos agropecuarios.
El congreso es organizando por la Secretaría de Agricultura, Ganadería y Pesca de la Nación, el Instituto Nacional de Tecnología Agropecuaria, el Instituto Nacional de Semillas (INASE), la Facultad de Agronomía de la Universidad Nacional del Centro de la Provincia de Buenos Aires (UNICEN) y el Ministerio de Desarrollo Agrario de la Provincia de Buenos Aires y se realiza el 3 y 4 de mayo en Azul -Buenos Aires-.
“La edición génica es una de las herramientas que permiten trabajar en el mejoramiento de cultivos para que puedan adaptarse al cambio climático”, señaló Sergio Feingold, director del Laboratorio de Agrobiotecnología del INTA, quien resaltó que también es una herramienta que permite el agregado de valor, “que es otro aspecto que se evalúa para despegar de la producción primaria”.
“La biotecnología no se reduce, ni se agota, en la generación de un organismo genéticamente modificado con resistencia a un herbicida”, señaló Feingold quien aseguró que “la edición génica permite una aproximación más racional a otros desarrollos que no necesariamente tienen que ver con la modificación genética de un cultivo”.

“Es un área de la ciencia que se apoya en los conocimientos existentes del mejoramiento convencional y la función de los genes”, subrayó Feingold y ejemplificó: “En la actualidad, la estamos aplicando al cultivo de papa para mejorar la calidad nutricional, la resistencia a golpes y mantener la mejor calidad posible durante el almacenamiento; esto generará beneficios para los productores, la industria y los consumidores al mantener una calidad homogénea y constante durante todo el año. Un aspecto que, sin dudas, permitirá un agregado de valor a la producción, junto con un aumento en la calidad nutricional del producto y una disminución del descarte de alimentos”.
Asimismo, se está trabajando en el desarrollo de cultivos, como alfalfa y lechuga, con resistencia a la sequía y mayor productividad, lo que mejorará la calidad de los cultivos y permitirá aumentar el aprovechamiento del cultivo para alimentación animal o humana.
La edición génica se presenta como una revolución que promete transformar la investigación en tecnologías agroindustriales. “Las capacidades científicas que existen hoy instaladas en el país son muy valiosas, son de alto profesionalismo y nos permiten estar a la vanguardia”, aseguró Feingold.
De acuerdo con la FAO, “la biotecnología incluye una amplia gama de tecnologías aplicadas a la agricultura, ganadería, silvicultura, pesca y acuicultura y la agroindustria que se utilizan para diversos fines, como el mejoramiento genético de plantas y animales para aumentar sus rendimientos o eficiencia; caracterización y conservación de los recursos genéticos para la alimentación y la agricultura; diagnóstico de enfermedades de plantas y animales, desarrollo de vacunas o la producción de alimentos fermentados”.
Congreso internacional
El 3 y 4 de mayo, en el Teatro Español de la ciudad Azul (Buenos Aires), se realizará el 9° Congreso de Agrobiotecnología, Propiedad Intelectual y Políticas Públicas. Un encuentro en el que participarán destacados disertantes del ámbito académico, de organismos públicos nacionales y provinciales, de organizaciones sectoriales y profesionales del sector privado.
Es organizado por la Secretaría de Agricultura, Ganadería y Pesca de la Nación, el Instituto Nacional de Tecnología Agropecuaria, el Instituto Nacional de Semillas (INASE), la Facultad de Agronomía de la Universidad Nacional del Centro de la Provincia de Buenos Aires (UNICEN) y el Ministerio de Desarrollo Agrario de la Provincia de Buenos Aires.
Durante dos jornadas, habrá exposiciones sobre agrobiotecnología, propiedad intelectual y políticas públicas, atravesadas desde distintos campos del conocimiento, como el derecho, el agropecuario y el económico, sin dejar de atender los adelantos en investigaciones e innovaciones.
Compartir